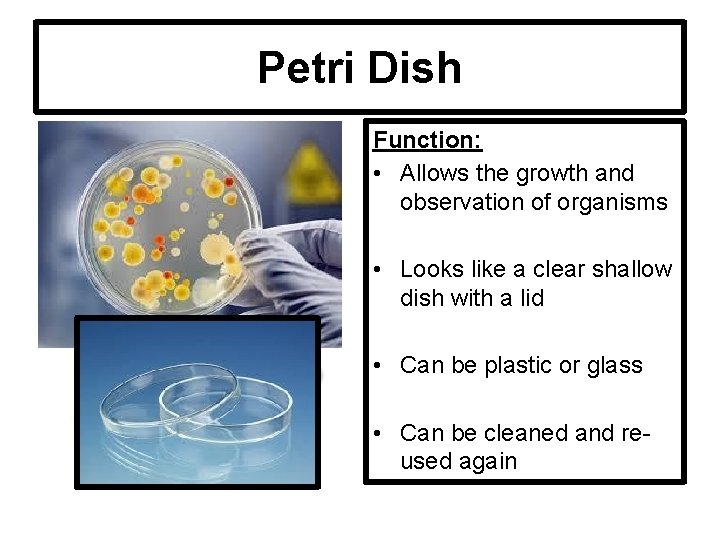
Petri Dish Function: • Allows the growth and observation of organisms • Looks like

Lab Equipment Introduction Beaker Function Provides an approximate

Lab Equipment Introduction

Beaker Function: Provides an approximate measurement of a liquid’s volume in liters (L) or millimeters (m. L). Sometimes we just use a CUP!

Pipette Comes in different lengths Function: • Transfers a small amount of liquid volume (drop by drop) by squeezing and releasing the bulb • NOT AN EYEDROPPER

Hand Lens Or Magnifying Lens Function: • Makes objects look bigger for observation • Can be plastic or glass

Funnel and Dropper Bottle Function: • Used to store and neatly dispense various liquids using the pipette or dropper • Another tool to help transport from container to container

Dissecting Equipment Function: • Helps to cut, observe, transfer, and examine biological specimens. • Includes: dissection needle, scissors, scalpel, forceps, Tpins and dissecting Pan

Test Tube Brush and Rack Function: • The brush is for proper cleaning of the test tubes • The rack securely holds the test tubes in place in an upright position

Test Tube Clamp Function: • Holds the test tube • Used when the test tube contains dangerous or hot chemicals

Flask Function: • Container for chemicals • Measures volume • Cylindrical neck allows liquids to be swirled

Graduated Cylinder Look closely Function: • Measures the volume of liquid in m. L • The liquid is measured at the meniscus (curved surface of the water)

Forceps and Tongs Function: • Both of these tools come in a variety of sizes and styles • They are used for grasping things that require precision
Petri Dish Function: • Allows the growth and observation of organisms • Looks like a clear shallow dish with a lid • Can be plastic or glass • Can be cleaned and reused again

Balance Mass, not Weight! Function: • Measures the mass of an object • Measurements are in grams • NOT A SCALE

Culture Dish Many sizes used Function: • A glass or plastic dish that biologists use to culture cells or hold specimens • Deeper than a petri but does not have a cover

Test Tube & Rubber Stopper Function: • Holds liquid chemicals • Glass or plastic tube with an open or stoppered end • Rubber stoppers can also be used on flasks

Microscope Slide, Cover Slip, and Depression Slide Function: • A microscope slide is a long thin piece of glass that specimens are placed on for study under a microscope • A depression slide has a concavity in one surface over which a cover glass can be placed and that is used in biology for hanging-drop cultures • Cover slips are small squares of glass that cover the specimen placed on the microscope slide

Microscope Function: • Uses objective lenses to magnify small objects for observation • Magnifications can vary • Carry using TWO HANDS one on arm and other under base

Hot Plate Function: • Heats chemicals or other lab objects • Powered by electricity, not fire

Thermometer Hot or Cold Function: • Measures temperature • Measurements reported in degrees Celsius

Goggles & Apron SAFETY and PROTECTION!!!

SAFETY for YOU and the Equipment! Broken Equipment Costs
- Slides: 21